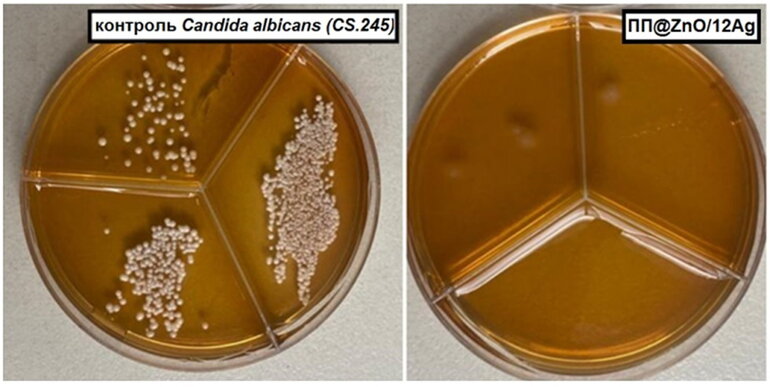
В Томске создали уникальную пищевую пленку, убивающую почти 100% бактерий

Физики Томского госуниверситета совместно с коллегами из Института физики прочности и материаловедения Сибирского отделения Российской академии наук (ИФПМ СО РАН) представили новую разработку для пищевой отрасли. Речь идет об антимикробной упаковочной пленке, которая способна уничтожать патогенные микроорганизмы на своей поверхности. Как сообщает пресс-служба ТГУ, эта технология не имеет отечественных аналогов и уже привлекла внимание крупных промышленных компаний.
Обычная полипропиленовая упаковка надежно оберегает продукты от влаги и кислорода, но не может противостоять размножению бактерий и плесени. Это серьезный недостаток, который сокращает сроки хранения и создает потенциальные риски для потребителей. Томские физики нашли решение, введя в состав полимера специальные наночастицы.
В качестве активного компонента исследователи использовали двухкомпонентные наночастицы оксида цинка и серебра (ZnO/Ag). Их уникальность — в синергетическом эффекте. Оксид цинка безопасен, но для работы часто требует ультрафиолета, а частицы серебра высокоэффективны, но могут мигрировать в пищу. Объединение этих материалов позволило получить мощный и при этом безопасный антимикробный агент.
«На сегодняшний день у отечественной промышленности нет серийного многотоннажного производства антимикробных упаковочных материалов для пищевой отрасли. Разработанная нами технология уже запатентована и готова к передаче от лаборатории в реальное производство. Интерес к ней проявили такие крупные промышленные компании, как «СИБУР ПолиЛаб» и НПП «Тасма»», — сказала старший научный сотрудник лаборатории нанотехнологий металлургии физико-технического факультета ТГУ Ольга Бакина.
Механизм действия пленки можно сравнить с работой микроскопических чистильщиков. Под действием обычного света — солнечного или искусственного в торговом зале — наночастицы генерируют активные формы кислорода. Они разрушают клеточные структуры бактерий и грибков, подавляя до 99,99% микроорганизмов. Такой эффект достигается даже при низкой концентрации наполнителя, что сохраняет экологичность и безопасность материала.
Ключ к успеху лежал в методе создания самих наночастиц. Их синтезировали с помощью электрического взрыва двух скрученных проволок в специальной газовой среде. Этот способ обеспечивает высокую чистоту продукта и позволяет получать частицы, где оксид цинка и серебро образуют четко разделенные фазы, что усиливает конечный эффект.
Для создания пленки гранулы полипропилена плавили, вводили в расплав наночастицы, а затем методом горячего прессования формировали композитный материал. Главной инженерной задачей было найти баланс: пленка должна была быть не только «стерильной», но и прочной, гибкой и пригодной для промышленного производства.
«Оптимальной «дозой» стали 0,5 мас.% наночастиц. При таком содержании достигается максимальная эффективность: пленка подавляет практически 100% рост микроорганизмов, сохраняя при этом все необходимые для упаковки прочностные свойства», — пояснила Бакина.
Эффективность материала проверили в лабораторных условиях на культурах золотистого стафилококка и дрожжеподобных грибов Candida albicans. Отдельные тесты на цитотоксичность подтвердили полную безопасность новой пленки для человека — контакт с материалом не наносил вреда живым клеткам.
Внедрение этой разработки может стать серьезным шагом для российской пищевой промышленности, снизив экономические потери от порчи продуктов и повысив их безопасность для конечного потребителя.












